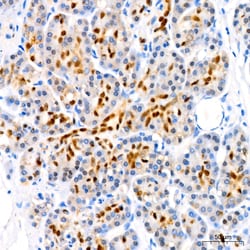
Invitrogen SOX9 Recombinant Rabbit Monoclonal Antibody (5Y4J8) 100 &mu;L;
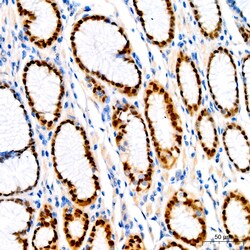
Invitrogen SOX9 Recombinant Rabbit Monoclonal Antibody (5Y4J8) 100 &mu;L;

Learn More
Invitrogen™ SOX9 Recombinant Rabbit Monoclonal Antibody (5Y4J8)


Rabbit Recombinant Monoclonal Antibody
Brand: Invitrogen™ MA542728
Description
Positive test controls include: HepG2, HeLa. The target is usually found in the following locations: Nucleus. Immunogen sequence: HPDYKYQPRR RKSVKNGQAE AEEATEQTHI SPNAIFKALQ ADSPHSSSGM SEVHSPGEHS GQSQGPPTPP TTPKTDVQPG KADLKREGRP LPEGGRQPPI DFRDVDIGEL SSDVISNIET FDVNEFDQYL PP.
SOX9 has a role in sex determination and differentiation of Sertoli cells. It is involved in chondrogenesis and regulates the expression of other genes involved in chondrogenesis by acting as a transcription factor for these genes. Translocation of this gene can cause campomelic dysplasia. SOX9 is involved in the formation of testes from the indifferent fetal gonads. It is a major molecular component of the neuron-glia switch in developing spinal cord. During normal development, SOX9 allows the prostate epithelium to outgrow into the mesenchyme and then provides basal cell support for development and maintenance of the luminal epithelium. These functions of SOX9 are subverted in prostate cancer to support tumor growth and invasion. SOX9 may direct the formation of neural crest precursors and the development of a range of neural crest derivative. It has a transcriptional regulation in melanin production in cells. Northern blot analysis shows its expression on adult testis, adult heart, and fetal brain.
Specifications
| SOX9 | |
| Recombinant Monoclonal | |
| 1 mg/mL | |
| PBS with 0.05% BSA, 50% glycerol and 0.02% sodium azide; pH 7.3 | |
| P48436, Q04887 | |
| SOX9 | |
| Recombinant protein (or fragment) | |
| 100 μL | |
| Primary | |
| Human, Mouse, Rat | |
| Antibody | |
| IgG |
| ELISA, Immunohistochemistry (Paraffin), Immunoprecipitation, Western Blot, Immunocytochemistry | |
| 5Y4J8 | |
| Unconjugated | |
| SOX9 | |
| 2010306G03Rik; AV220920; CMD1; CMPD1; mKIAA4243; SOX 9; Sox9; SOX-9; Sox9 transcription factor; SRA1; SRXX2; SRXY10; SRY (sex determining region Y)-box 9; SRY (sex determining region Y)-box 9 (campomelic dysplasia, autosomal sex-reversal); SRY (sex determining region Y)-box9; SRY (sex-determining region Y)-box 9 protein; SRY box 9; SRY-box 9; SRY-Box 9 ; SRY-box containing 9; SRY-box containing gene 9; SRY-box containing protein 9; SRY-box transcription factor 9; SRY-related HMG-box, gene 9; transcription activator Sox9; transcription factor SOX-9 | |
| Rabbit | |
| Affinity Chromatography | |
| RUO | |
| 140586, 20682, 6662 | |
| -20°C, Avoid Freeze/Thaw Cycles | |
| Liquid |
Your input is important to us. Please complete this form to provide feedback related to the content on this product.